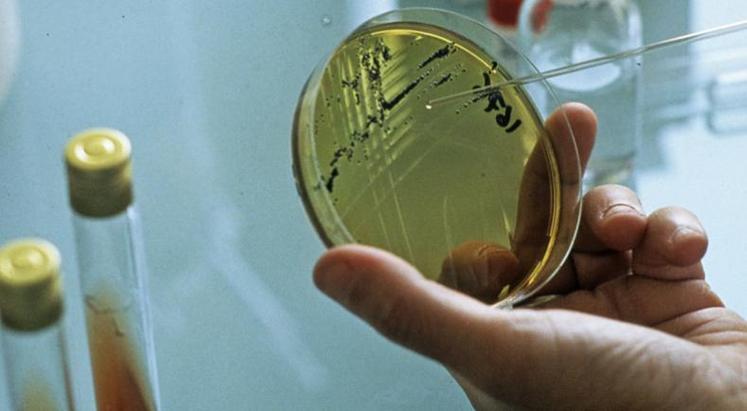

Lancement d'une unité de recherche sur la qualité des fruits et légumes après récolte
La filière fruits et légumes française se dote d’un «nouvel outil pour renforcer les travaux de recherche sur la qualité post-récolte».
L’unité mixte technologique (UMT) Iquar (Innover pour la qualité après récolte) a reçu «mi-janvier» l’agrément nécessaire de la part du ministère de l’Agriculture, annoncent les deux organismes fondateurs - le CTIFL et l’Université d’Avignon - ainsi que les partenaires - Inra et Cirad - dans un communiqué le 1er février. L’UMT tendra à «répondre aux multiples enjeux de la filière sur le maintien d’une production nationale significative et de qualité pour le consommateur, la réduction des pertes et du gaspillage, et le développement des produits issus de l’agriculture biologique et raisonnée pour limiter l’utilisation d’intrants».